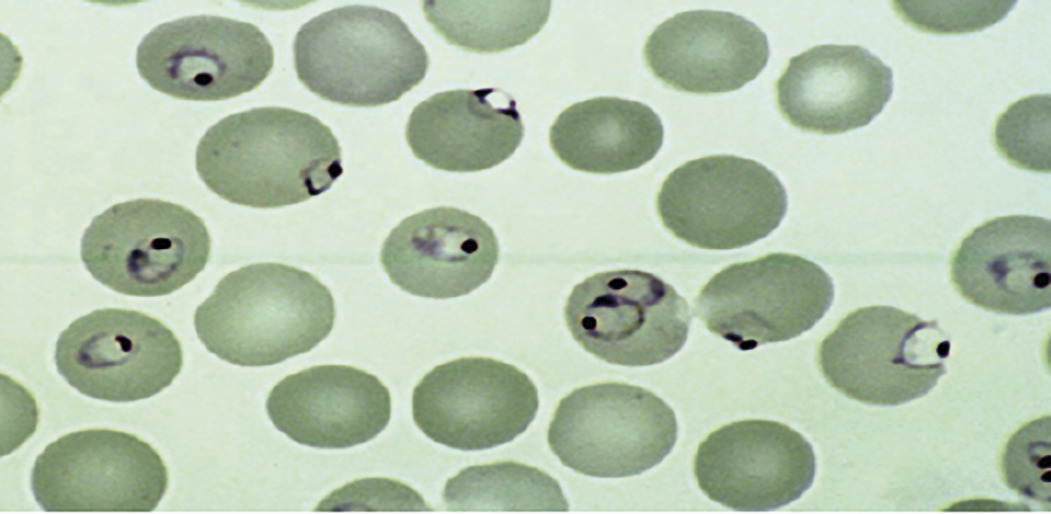

à évoquer devant toute fièvre au retour de zone tropicale.
Cette infection parasitaire est transmise essentiellement en Afrique subsaharienne. Elle reste une préoccupation pour le voyageur, en raison de sa relative fréquence et de sa gravité potentielle.. La Société de pathologie infectieuse de langue française (SPILF), avec la Société de médecine des voyages et la Société française de parasitologie, publie environ tous les 10 ans des recommandations pour tenir compte des évolutions épidémiologiques, diagnostiques et thérapeutiques. Les dernières datent de juin 2017,1 et ont été reprises en grande partie dans le dernier numéro du BEH (mai 2018).2
Incidence : en baisse
La situation épidémiologique s’est améliorée en zone d’endémie grâce à des efforts considérables (meilleur accès à de nouveaux traitements plus efficaces, tests rapides permettant des diagnostics plus précoces, distribution de moustiquaires imprégnées d’insecticides, lutte antivectorielle, etc.) rendus possibles par un financement international conséquent sous la houlette de l’OMS (programme Roll Back Malaria).
Même si l’incidence est vraisemblablement sous-évaluée, la réduction du nombre de cas dans le monde sur les 15 dernières années est estimée à 41 %, avec une chute spectaculaire des décès (62 % au total et 71 % en Afrique).3 Cette baisse de mortalité s’explique par une prise en charge plus précoce des moins de 5 ans, qui sont particulièrement concernés par les formes graves (90 % des enfants mouraient avant d’avoir pu atteindre un centre de santé). Actuellement, le paludisme est endémique dans 91 pays (dont 43 en Afrique subsaharienne), avec plus de 200 millions de nouveaux cas et un peu moins de 500 000 décès par an. L’Afrique subsaharienne, et notamment la région forestière centrale (république démocratique du Congo, Nigeria…), est de très loin la plus touchée : 90 % de l’ensemble des cas mondiaux et 92 % des décès, dus pour l’essentiel à Plasmodium falciparum.
Ce bilan plutôt optimiste ne doit pas faire oublier que le paludisme est encore un problème de santé publique majeur et que ces acquis restent fragiles car dépendant notamment de la solidarité internationale. Outre le risque de baisse des financements, deux facteurs menacent ces succès : l’émergence de la résistance de P. falciparum aux nouveaux traitements à base d’artémisinine et celle des anophèles vecteurs aux insecticides. D’ailleurs, les toutes dernières tendances montrent une stabilisation des gains épidémiologiques, voire une régression dans certains pays…
Même si l’incidence est vraisemblablement sous-évaluée, la réduction du nombre de cas dans le monde sur les 15 dernières années est estimée à 41 %, avec une chute spectaculaire des décès (62 % au total et 71 % en Afrique).3 Cette baisse de mortalité s’explique par une prise en charge plus précoce des moins de 5 ans, qui sont particulièrement concernés par les formes graves (90 % des enfants mouraient avant d’avoir pu atteindre un centre de santé). Actuellement, le paludisme est endémique dans 91 pays (dont 43 en Afrique subsaharienne), avec plus de 200 millions de nouveaux cas et un peu moins de 500 000 décès par an. L’Afrique subsaharienne, et notamment la région forestière centrale (république démocratique du Congo, Nigeria…), est de très loin la plus touchée : 90 % de l’ensemble des cas mondiaux et 92 % des décès, dus pour l’essentiel à Plasmodium falciparum.
Ce bilan plutôt optimiste ne doit pas faire oublier que le paludisme est encore un problème de santé publique majeur et que ces acquis restent fragiles car dépendant notamment de la solidarité internationale. Outre le risque de baisse des financements, deux facteurs menacent ces succès : l’émergence de la résistance de P. falciparum aux nouveaux traitements à base d’artémisinine et celle des anophèles vecteurs aux insecticides. D’ailleurs, les toutes dernières tendances montrent une stabilisation des gains épidémiologiques, voire une régression dans certains pays…
Lire aussi | Dossier progressif n° 268
Cas importés en France
Reflet logique de ce qui se passe en zone d’endémie, le paludisme d’importation provient essentiellement d’Afrique subsaharienne (95 %) et est principalement dû à P. falciparum.4 Entre 2000 et 2013, le nombre de cas annuels a baissé de moitié5 mais il remonte depuis (4 500 cas environ en 2017).
Le risque d’acquérir un paludisme est 1 000 fois plus important en Afrique subsaharienne (0,5 à 3 % par mois d’exposition) qu’en Asie ou en Amérique du Sud (environ 1 pour 100 000). Cela explique en partie que trois quarts des cas en France sont des migrants africains faisant un séjour au pays. Le nombre de formes graves a tendance à augmenter, sans qu’il y ait d’explications très claires (12 % de l’ensemble des cas en 2015).
Dans la France outre-mer « tropicale », seuls deux territoires sont concernés : Mayotte, où la transmission semble en voie d’extinction, et la Guyane, qui a vu l’incidence chuter pendant la dernière décennie avec actuellement environ 500 cas annuels, surtout liés à Plasmodium vivax (en dehors des zones d’orpaillage clandestin).
Le risque d’acquérir un paludisme est 1 000 fois plus important en Afrique subsaharienne (0,5 à 3 % par mois d’exposition) qu’en Asie ou en Amérique du Sud (environ 1 pour 100 000). Cela explique en partie que trois quarts des cas en France sont des migrants africains faisant un séjour au pays. Le nombre de formes graves a tendance à augmenter, sans qu’il y ait d’explications très claires (12 % de l’ensemble des cas en 2015).
Dans la France outre-mer « tropicale », seuls deux territoires sont concernés : Mayotte, où la transmission semble en voie d’extinction, et la Guyane, qui a vu l’incidence chuter pendant la dernière décennie avec actuellement environ 500 cas annuels, surtout liés à Plasmodium vivax (en dehors des zones d’orpaillage clandestin).
Lire aussi | Paludisme
Nouveautés dans le diagnostic ?
à côté du classique examen direct d’un frottis sanguin (visualisation des parasites à l’intérieur des hématies permettant d’identifier l’espèce et de quantifier le nombre de cellules parasitées ; fig. 1) complété par une goutte épaisse (meilleure sensibilité mais réalisation plus complexe), on dispose aujourd’hui de tests de diagnostic rapide (TDR) et de techniques de détection par PCR.
Les TDR (fig. 2 ), dont les performances sont désormais équivalentes à celle d’un frottis, ont l’avantage de ne pas être opérateur-dépendants. Ainsi, dans les laboratoires non spécialisés, qui ne disposent pas toujours de l’expertise nécessaire pour réaliser et interpréter l’examen direct, on peut « débrouiller » le diagnostic par un TDR en l’associant à un frottis sanguin. Plusieurs techniques étant disponibles, ces tests doivent obligatoirement détecter la protéine HRP2, spécifique de P. falciparum. Le diagnostic étant une urgence (chaque heure compte, a fortiori dans les formes graves), le laboratoire doit être en mesure de rendre le résultat au praticien dans les 2 heures suivant l’arrivée du tube. Si positif, il doit être obligatoirement communiqué directement (traçabilité recommandée).
Les antigènes persistant plusieurs semaines dans le sang (même après élimination des parasites), les TDR ne peuvent pas être utilisés pour le suivi. Sauf situation particulière, ils ne sont pas recommandés en autodiagnostic : dans un contexte de stress lié à la fièvre, les difficultés techniques de réa- lisation et d’interprétation du résultat (confusion entre bande témoin et résultat positif) conduisent à des erreurs potentiellement délétères.
Que ce soit avec le frottis sanguin-goutte épaisse ou le TDR, un résultat négatif et a fortiori douteux ne permet pas d’éliminer le diagnostic. Selon le contexte clinique, il faut réitérer l’examen 12 à 24 heures plus tard, éventuellement après avoir initié un traitement présomptif en cas de signes de gravité. Un diagnostic parasitologique peut se faire à tout moment, y compris en dehors d’un accès fébrile.
La quantification de la parasitémie (possible sur le frottis ou la goutte épaisse mais pas avec les TDR) est importante pour déterminer la gravité (plus de 4 % d’hématies parasitées) et guide la thérapeutique (hospitalisation indispensable si > 2 % ; suivi de l’efficacité sous traitement). Les anticorps palustres n’apparaissant que tardivement et le résultat demandant plusieurs jours, la prescription d’une sérologie en cas de fièvre serait une erreur potentiellement lourde de conséquences pour le patient.
L’hémogramme peut orienter : une thrombopénie et à un moindre degré l’absence d’hyperleucocytose ou une baisse même modérée de l’hémoglobine (témoin de l’hémolyse) sont évocateurs.
La PCR est la technique la plus sensible et spécifique pour le diagnostic du paludisme d’importation. Son utilisation en routine pose cependant des problèmes non encore résolus (délai de réalisation incompatible avec l’urgence, sensibilité « excessive », absence de quantification de la parasitémie). Les toutes nouvelles méthodes rapides (résultats en moins de 1 heure) sont très intéressantes mais il faut savoir que l’apport essentiel de la PCR tient à sa valeur prédictive négative au moment du prélèvement. Elle ne permet pas le suivi sous traitement (persistance prolongée de l’ADN parasitaire).
Les TDR (
Les antigènes persistant plusieurs semaines dans le sang (même après élimination des parasites), les TDR ne peuvent pas être utilisés pour le suivi. Sauf situation particulière, ils ne sont pas recommandés en autodiagnostic : dans un contexte de stress lié à la fièvre, les difficultés techniques de réa- lisation et d’interprétation du résultat (confusion entre bande témoin et résultat positif) conduisent à des erreurs potentiellement délétères.
Que ce soit avec le frottis sanguin-goutte épaisse ou le TDR, un résultat négatif et a fortiori douteux ne permet pas d’éliminer le diagnostic. Selon le contexte clinique, il faut réitérer l’examen 12 à 24 heures plus tard, éventuellement après avoir initié un traitement présomptif en cas de signes de gravité. Un diagnostic parasitologique peut se faire à tout moment, y compris en dehors d’un accès fébrile.
La quantification de la parasitémie (possible sur le frottis ou la goutte épaisse mais pas avec les TDR) est importante pour déterminer la gravité (plus de 4 % d’hématies parasitées) et guide la thérapeutique (hospitalisation indispensable si > 2 % ; suivi de l’efficacité sous traitement). Les anticorps palustres n’apparaissant que tardivement et le résultat demandant plusieurs jours, la prescription d’une sérologie en cas de fièvre serait une erreur potentiellement lourde de conséquences pour le patient.
L’hémogramme peut orienter : une thrombopénie et à un moindre degré l’absence d’hyperleucocytose ou une baisse même modérée de l’hémoglobine (témoin de l’hémolyse) sont évocateurs.
La PCR est la technique la plus sensible et spécifique pour le diagnostic du paludisme d’importation. Son utilisation en routine pose cependant des problèmes non encore résolus (délai de réalisation incompatible avec l’urgence, sensibilité « excessive », absence de quantification de la parasitémie). Les toutes nouvelles méthodes rapides (résultats en moins de 1 heure) sont très intéressantes mais il faut savoir que l’apport essentiel de la PCR tient à sa valeur prédictive négative au moment du prélèvement. Elle ne permet pas le suivi sous traitement (persistance prolongée de l’ADN parasitaire).
Prise en charge de l’accès
L’étape décisive pour éviter les retards au traitement – encore trop fréquents – est d’évoquer le diagnostic !
Toute fièvre au retour de zone tropicale est un paludisme jusqu’à preuve du contraire. Celle-ci étant irrégulière (évolution par pics liés au cycle parasitaire même si les classiques fièvres tierces ou quartes sont décrites surtout dans les livres), toute histoire de fièvre récente rapportée par un patient est à considérer. Il faut rechercher la notion de voyage tropical (notamment en Afrique) dont le patient revient en règle depuis quelques jours ou semaines (rarement depuis plus de 2 mois). Les autres symptômes sont peu spécifiques, de type « syndrome grippal » (source de diagnostic erroné en période hivernale !) ; céphalées et troubles digestifs (surtout chez l’enfant, évoquant à tort une entérite) sont fréquents.
Les signes de gravité doivent être recherchés. Si certains sont évidents (état de choc, détresse respiratoire, coma…), ils peuvent retarder le diag-nostic, surtout si le patient n’est pas en mesure d’expliquer le contexte. Des troubles cérébraux même minimes (confusion, ralentissement psychique…) sont également inquiétants. Ils imposent une hospitalisation en extrême urgence (Samu si diagnostic évoqué en ville), un décès étant possible en quelques heures seulement.
Une confirmation biologique (avec rendu du résultat) est indispensable dans les plus brefs délais. Une fois le diagnostic posé (contact direct entre prescripteur et biologiste), le traitement doit être initié immédiatement. L’hospitalisation n’est pas indispensable mais recommandée (aggravation brutale possible). Cependant, des critères de prise en charge en ambulatoire sont proposés dans les recommandations, le bon sens voulant que le prescripteur s’assure de la disponibilité de l’antipaludique dans la pharmacie de proximité.
En l’absence de signe de gravité (accès palustre simple ou non compliqué), les bithérapies incluant un dérivé de l’artémisinine (artemisinin-based combination therapy ou ACT) sont devenues la référence. Deux produits sont disponibles en France : l’arténimol-pipéraquine (Eurartesim) et l’arté- méther-luméfantrine (Riamet). Ils ont des profils d’efficacité et de tolérance comparables (tableau 1) même si le premier a l’avantage d’une posologie plus simple et peut être pris à jeun (nausées et vomissements fréquents dans le paludisme) ; ils partagent les mêmes contre-indications cardiaques (risque d’allongement de l’espace QTc).
L’atovaquone-proguanil (Malarone) n’est plus recommandé en première ligne (tableau 1) mais seulement en cas de contre-indication aux 2 ACT ; il a en effet une activité parasiticide plus lente et des effets indésirables, notamment digestifs, plus fréquents.
En cas d’accès palustre lié à une espèce non falciparum (P. vivax, ovale, malariae, exceptionnellement knowlesi), si la classique chloroquine (Nivaquine) reste active, les nouvelles recommandations proposent d’utiliser l’une des deux ACT. Pour P. vivax et ovale (possibilité de reviviscence après plusieurs mois ou années à cause d’un réservoir hépatique d’hypnozoïtes non éradiqué lors de la prise en charge initiale), un traitement complémentaire par primaquine est recommandé en milieu spécialisé (disponible en ATU, risque d’hémolyse grave si déficit en G6PD).
La conduite à tenir est la même chez l’enfant, en dehors d’une gestion initiale impérative en milieu hospitalier, au mieux spécialisé, et de la possibilité d’utiliser la méfloquine (Lariam) en 2e ligne.
Une surveillance clinique et biologique incluant un frottis-goutte épaisse est recommandée à J3 (la parasitémie doit être < 25 % de la valeur initiale) et à J7 (elle doit être négative). Un contrôle à J 28 est également conseillé. La présence de gamétocytes après traitement ne justifie pas une seconde cure d’antipaludiques. Il n’est pas nécessaire de reprendre une chimioprophylaxie après un traitement curatif complet (sauf si nouveau séjour en zone d’endémie).
En cas d’accès grave, la référence est maintenant l’artésunate IV (efficacité meilleure que la quinine IV). C’est évidemment une affaire de spécialiste y compris pour le suivi (risque d’anémie hémolytique différée).
Toute fièvre au retour de zone tropicale est un paludisme jusqu’à preuve du contraire. Celle-ci étant irrégulière (évolution par pics liés au cycle parasitaire même si les classiques fièvres tierces ou quartes sont décrites surtout dans les livres), toute histoire de fièvre récente rapportée par un patient est à considérer. Il faut rechercher la notion de voyage tropical (notamment en Afrique) dont le patient revient en règle depuis quelques jours ou semaines (rarement depuis plus de 2 mois). Les autres symptômes sont peu spécifiques, de type « syndrome grippal » (source de diagnostic erroné en période hivernale !) ; céphalées et troubles digestifs (surtout chez l’enfant, évoquant à tort une entérite) sont fréquents.
Les signes de gravité doivent être recherchés. Si certains sont évidents (état de choc, détresse respiratoire, coma…), ils peuvent retarder le diag-nostic, surtout si le patient n’est pas en mesure d’expliquer le contexte. Des troubles cérébraux même minimes (confusion, ralentissement psychique…) sont également inquiétants. Ils imposent une hospitalisation en extrême urgence (Samu si diagnostic évoqué en ville), un décès étant possible en quelques heures seulement.
Une confirmation biologique (avec rendu du résultat) est indispensable dans les plus brefs délais. Une fois le diagnostic posé (contact direct entre prescripteur et biologiste), le traitement doit être initié immédiatement. L’hospitalisation n’est pas indispensable mais recommandée (aggravation brutale possible). Cependant, des critères de prise en charge en ambulatoire sont proposés dans les recommandations, le bon sens voulant que le prescripteur s’assure de la disponibilité de l’antipaludique dans la pharmacie de proximité.
En l’absence de signe de gravité (accès palustre simple ou non compliqué), les bithérapies incluant un dérivé de l’artémisinine (artemisinin-based combination therapy ou ACT) sont devenues la référence. Deux produits sont disponibles en France : l’arténimol-pipéraquine (Eurartesim) et l’arté- méther-luméfantrine (Riamet). Ils ont des profils d’efficacité et de tolérance comparables (tableau 1) même si le premier a l’avantage d’une posologie plus simple et peut être pris à jeun (nausées et vomissements fréquents dans le paludisme) ; ils partagent les mêmes contre-indications cardiaques (risque d’allongement de l’espace QTc).
L’atovaquone-proguanil (Malarone) n’est plus recommandé en première ligne (tableau 1) mais seulement en cas de contre-indication aux 2 ACT ; il a en effet une activité parasiticide plus lente et des effets indésirables, notamment digestifs, plus fréquents.
En cas d’accès palustre lié à une espèce non falciparum (P. vivax, ovale, malariae, exceptionnellement knowlesi), si la classique chloroquine (Nivaquine) reste active, les nouvelles recommandations proposent d’utiliser l’une des deux ACT. Pour P. vivax et ovale (possibilité de reviviscence après plusieurs mois ou années à cause d’un réservoir hépatique d’hypnozoïtes non éradiqué lors de la prise en charge initiale), un traitement complémentaire par primaquine est recommandé en milieu spécialisé (disponible en ATU, risque d’hémolyse grave si déficit en G6PD).
La conduite à tenir est la même chez l’enfant, en dehors d’une gestion initiale impérative en milieu hospitalier, au mieux spécialisé, et de la possibilité d’utiliser la méfloquine (Lariam) en 2e ligne.
Une surveillance clinique et biologique incluant un frottis-goutte épaisse est recommandée à J3 (la parasitémie doit être < 25 % de la valeur initiale) et à J7 (elle doit être négative). Un contrôle à J 28 est également conseillé. La présence de gamétocytes après traitement ne justifie pas une seconde cure d’antipaludiques. Il n’est pas nécessaire de reprendre une chimioprophylaxie après un traitement curatif complet (sauf si nouveau séjour en zone d’endémie).
En cas d’accès grave, la référence est maintenant l’artésunate IV (efficacité meilleure que la quinine IV). C’est évidemment une affaire de spécialiste y compris pour le suivi (risque d’anémie hémolytique différée).
Chimioprophylaxie (CP) : simplifiée !
La prévention comprend 3 niveaux complémentaires : prophylaxie personnelle antivectorielle (PPAV) recommandée dans tous les cas, CP et connaissance de la maladie, qui incite le voyageur à consulter très rapidement en cas de fièvre, que ce soit sur place ou au retour (un diagnostic précoce et un traitement rapide permettent de prévenir les formes graves).
La PPAV qui, pour le paludisme, n’a de sens que la nuit (et plutôt tard dans la soirée), du fait de l’activité essentiellement nocturne des anophèles femelles – seules transmettrices des plasmodies – repose sur : moustiquaire pour dormir, répulsifs cutanés et imprégnation des vêtements. La moustiquaire, surtout imbibée d’insecticides (barrière chimique et mécanique), est le moyen de loin le plus efficace, sa limite résidant dans la contrainte liée à son transport et son installation. L’application de répulsifs est en pratique la stratégie la plus utilisée. Leur efficacité dépend du produit actif et de sa concentration. Ils sont appliqués sur les parties exposées aux piqûres, 1 ou 2 fois selon la durée de la soirée (l’effet dure en moyenne 6 heures mais il y a de grandes variations d’une personne à l’autre). Leur toxicité est faible mais des restrictions s’appliquent chez l’enfant et la femme enceinte (tableau 2). Imprégner les vêtements est un moyen sous-utilisé et pourtant intéressant, en complément des répulsifs. Si c’est fait par trempage, l’effet persiste jusqu’à 5 lavages (2 si pulvérisation), ce qui permet une préparation avant le départ.
Des produits insecticides en aérosol peuvent être utilisés de façon ponctuelle. Les serpentins ne doivent être employés que sur une période courte et en extérieur. La ventilation et la climatisation (surtout individuelle) ont une efficacité relative. Les insecticides diffusibles d’intérieur ont un intérêt modéré, en particulier lors des séjours prolongés. Bracelets imprégnés, émetteurs d’ultrasons, produits homéopathiques, vitamino-thérapie et huiles essentielles n’ont pas fait la preuve de leur efficacité.
La chimioprophylaxie n’a pratiquement plus d’indications hors Afrique subsaharienne, notamment en Asie et Amérique tropicales (tableau 3). Outre le fait que la majorité des paludismes à P. falciparum surviennent lors de séjours de plus de 1 mois, dans ces 2 continents le risque est 1 000 fois plus faible (par rapport à l’Afrique subsaharienne) et P. falciparum n’est pas trans- mis en zone urbaine. Ainsi, un séjour avec la totalité ou l’essentiel des nuitées en ville (quelques nuitées en zone rurale ne remet pas en cause l’abstention) ne justifie pas de CP, a fortiori s’il est court (majorité des voyages dits « conventionnels ») car la balance bénéfice- risque ne serait pas favorable. Dans des conditions d’isolement (trek…), un traitement de réserve (ou présomptif d’urgence) qui consiste à prendre une thérapie curative de 1re ligne en cas de fièvre et impossibilité d’avoir un diagnostic fiable dans les 12 heures, peut se discuter, idéalement après avis spécialisé.
En Afrique subsaharienne, la CP est toujours recommandée (sauf situation particulière relevant des spécialistes) y compris chez les migrants (fausse notion d’une protection « naturelle »).
En cas de séjour prolongé ou expatriation, le risque étant proportionnel à la durée d’exposition, la CP peut être maintenue pendant toute leur durée (y compris quelques années) si le risque le justifie (Afrique subsaharienne). L’apparition d’une intolérance est en règle très rare au-delà des 2 à 3 premiers mois. Atovaquone-proguanil (hors AMM après 3 mois, cette limite française étant d’ordre administratif), doxycycline, méfloquine peuvent être prescrites sans limitation de temps. La difficulté étant d’apprécier le risque lorsqu’on vit sur place, on recommande aux voyageurs et expatriés une CP initiale de 3-6 mois puis d’évaluer auprès d’une source fiable la pertinence de la prolonger. En zone sahélienne, la CP peut se limiter à couvrir la saison des pluies, en poursuivant 1,5 mois après sa fin (CP saisonnière). L’identification d’un référent médical local est recommandée (conseils, diagnostic, traitement en cas de fièvre).
Les indications de chloroquine (Nivaquine) et de chloroquine-proguanil (Savarine) étant maintenant extrêmement restreintes, le choix des antipaludiques préventifs se limite en pratique à l’atovaquone-proguanil, la doxycycline et la méfloquine. Ils ont une efficacité élevée et comparable. Le choix dépend essentiellement des finances des voyageurs et des contraintes de prise (tolérance et simplicité du schéma ; tableaux 4 et 5).
La méfloquine est la moins bien tolérée des trois (effets indésirables graves plus fréquents). Compte tenu de la balance bénéfice-risque, il est souhaitable de limiter sa prescription aux séjours prolongés à risque élevé lorsque la prise hebdomadaire représente un vrai gage d’efficacité ou en cas d’impossibilité de prescrire atovaquone- proguanil ou doxycycline.
Devant la généralisation des résistances à la chloroquine et au proguanil et l’efficacité de ces 3 antipaludiques sur la majorité des souches de plasmodies, la classique distinction des pays en 3 groupes selon le niveau de résistance a disparu.
La PPAV qui, pour le paludisme, n’a de sens que la nuit (et plutôt tard dans la soirée), du fait de l’activité essentiellement nocturne des anophèles femelles – seules transmettrices des plasmodies – repose sur : moustiquaire pour dormir, répulsifs cutanés et imprégnation des vêtements. La moustiquaire, surtout imbibée d’insecticides (barrière chimique et mécanique), est le moyen de loin le plus efficace, sa limite résidant dans la contrainte liée à son transport et son installation. L’application de répulsifs est en pratique la stratégie la plus utilisée. Leur efficacité dépend du produit actif et de sa concentration. Ils sont appliqués sur les parties exposées aux piqûres, 1 ou 2 fois selon la durée de la soirée (l’effet dure en moyenne 6 heures mais il y a de grandes variations d’une personne à l’autre). Leur toxicité est faible mais des restrictions s’appliquent chez l’enfant et la femme enceinte (tableau 2). Imprégner les vêtements est un moyen sous-utilisé et pourtant intéressant, en complément des répulsifs. Si c’est fait par trempage, l’effet persiste jusqu’à 5 lavages (2 si pulvérisation), ce qui permet une préparation avant le départ.
Des produits insecticides en aérosol peuvent être utilisés de façon ponctuelle. Les serpentins ne doivent être employés que sur une période courte et en extérieur. La ventilation et la climatisation (surtout individuelle) ont une efficacité relative. Les insecticides diffusibles d’intérieur ont un intérêt modéré, en particulier lors des séjours prolongés. Bracelets imprégnés, émetteurs d’ultrasons, produits homéopathiques, vitamino-thérapie et huiles essentielles n’ont pas fait la preuve de leur efficacité.
La chimioprophylaxie n’a pratiquement plus d’indications hors Afrique subsaharienne, notamment en Asie et Amérique tropicales (tableau 3). Outre le fait que la majorité des paludismes à P. falciparum surviennent lors de séjours de plus de 1 mois, dans ces 2 continents le risque est 1 000 fois plus faible (par rapport à l’Afrique subsaharienne) et P. falciparum n’est pas trans- mis en zone urbaine. Ainsi, un séjour avec la totalité ou l’essentiel des nuitées en ville (quelques nuitées en zone rurale ne remet pas en cause l’abstention) ne justifie pas de CP, a fortiori s’il est court (majorité des voyages dits « conventionnels ») car la balance bénéfice- risque ne serait pas favorable. Dans des conditions d’isolement (trek…), un traitement de réserve (ou présomptif d’urgence) qui consiste à prendre une thérapie curative de 1re ligne en cas de fièvre et impossibilité d’avoir un diagnostic fiable dans les 12 heures, peut se discuter, idéalement après avis spécialisé.
En Afrique subsaharienne, la CP est toujours recommandée (sauf situation particulière relevant des spécialistes) y compris chez les migrants (fausse notion d’une protection « naturelle »).
En cas de séjour prolongé ou expatriation, le risque étant proportionnel à la durée d’exposition, la CP peut être maintenue pendant toute leur durée (y compris quelques années) si le risque le justifie (Afrique subsaharienne). L’apparition d’une intolérance est en règle très rare au-delà des 2 à 3 premiers mois. Atovaquone-proguanil (hors AMM après 3 mois, cette limite française étant d’ordre administratif), doxycycline, méfloquine peuvent être prescrites sans limitation de temps. La difficulté étant d’apprécier le risque lorsqu’on vit sur place, on recommande aux voyageurs et expatriés une CP initiale de 3-6 mois puis d’évaluer auprès d’une source fiable la pertinence de la prolonger. En zone sahélienne, la CP peut se limiter à couvrir la saison des pluies, en poursuivant 1,5 mois après sa fin (CP saisonnière). L’identification d’un référent médical local est recommandée (conseils, diagnostic, traitement en cas de fièvre).
Les indications de chloroquine (Nivaquine) et de chloroquine-proguanil (Savarine) étant maintenant extrêmement restreintes, le choix des antipaludiques préventifs se limite en pratique à l’atovaquone-proguanil, la doxycycline et la méfloquine. Ils ont une efficacité élevée et comparable. Le choix dépend essentiellement des finances des voyageurs et des contraintes de prise (tolérance et simplicité du schéma ; tableaux 4 et 5).
La méfloquine est la moins bien tolérée des trois (effets indésirables graves plus fréquents). Compte tenu de la balance bénéfice-risque, il est souhaitable de limiter sa prescription aux séjours prolongés à risque élevé lorsque la prise hebdomadaire représente un vrai gage d’efficacité ou en cas d’impossibilité de prescrire atovaquone- proguanil ou doxycycline.
Devant la généralisation des résistances à la chloroquine et au proguanil et l’efficacité de ces 3 antipaludiques sur la majorité des souches de plasmodies, la classique distinction des pays en 3 groupes selon le niveau de résistance a disparu.
Références
1. SPILF. Prise en charge et prévention du paludisme d’importation. Mise à jour 2017 des RPC 2007.
https://bit.ly/2JJ7eE6
2. BEH hors-série. Recommandations sanitaires pour les voyageurs, 2018.
https://bit.ly/2LKsTNK
3. OMS. Rapport sur le paludisme dans le monde 2017.
https://bit.ly/2yd5BNW
4. Centre National de Référence du Paludisme pour la France métropolitaine.
https://bit.ly/2MrBjKb
5. van Rijckevorsel GG, Sonder GJ, Geskus RB, et al. Declining incidence of imported malaria in the Netherlands, 2000-2007. Malar J 2010;9:300.
https://bit.ly/2JJ7eE6
2. BEH hors-série. Recommandations sanitaires pour les voyageurs, 2018.
https://bit.ly/2LKsTNK
3. OMS. Rapport sur le paludisme dans le monde 2017.
https://bit.ly/2yd5BNW
4. Centre National de Référence du Paludisme pour la France métropolitaine.
https://bit.ly/2MrBjKb
5. van Rijckevorsel GG, Sonder GJ, Geskus RB, et al. Declining incidence of imported malaria in the Netherlands, 2000-2007. Malar J 2010;9:300.